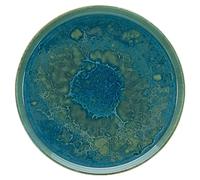
Creatable, 21508 Serie Yuki - Platos llanos (4 piezas)

21508 - Juego de direccion Negra Orbit Equipe 1-1/8
38,17 €
Amazon Marketplace (ES)
Envío a partir de 19,90 €

Ajusa 54129700 Juego de juntas, Parte baja
80,96 €
amazon.es
sin gastos de envío

Juego de cojinetes de montaje inferior para radiador (2 piezas) para Nissan Frontier 1998-2015 - Cojinetes de goma, componente de moldura de repuesto directo para interior de coche
9,49 €
Amazon Marketplace (ES)
sin gastos de envío

Ajusa 50285000 Juego completo de juntas, motor
256,23 €
amazon.es
sin gastos de envío

Ajusa 57023100 Juego Reténes Válvula
24,24 €
amazon.es
Envío a partir de 3,99 €

MAPCO Bomba de agua para MAZDA: 3, 2 (Ref: 21508)
49,60 €
oscaro.es
Envío a partir de 7,99 €
Creatable, 21508 Serie Yuki - Platos llanos (4 piezas)
81,34 €
20.34 EUR/1.0 unidad
amazon.es
sin gastos de envío

Autentica LOTERIA Mexican Bingo Set 20 Tablets Colorful and Educational! by Natorytian
27,34 €
Amazon Marketplace (ES)
sin gastos de envío
🤖 Pregunta a ChatGPT
🛍️ ¿Cuáles son los criterios de compra más importantes?
💰 ¡Dime cuáles son las mejores ofertas!
📋 ¡Haz un breve resumen!
Información acerca de "21508 juego de"
Compara las 13 los precios para "21508 juego de".
Hemos encontrado ofertas de 38 categorías, con un rango de precio entre 9,49 € y 256,23 €.
Datos de "21508 juego de"
- El artículo que deseas, "21508 juego de", está disponible en 3 tiendas virtuales, como Amazon Marketplace (ES), amazon.es y oscaro.es.
- De entre todos los fabricantes puedes seleccionar 4 proveedores, entre los que destacan FSA, Ajusa, Mapco y CreaTable.
- Con un precio alrededor de 39,00 € - 39,99 € se encuentra el mayor número de productos (3).
- Además, también pueden interesarte .
- Con nuestra amplia paleta de colores puedes encontrar el artículo que buscas en tu color favorito. De entre las 3 tonalidades disponibles, el color negro es el más utilizado.
No olvides tu cupón descuento:
Denunciar infracción
Está a punto de denunciar una infracción legal en base a la Ley de Servicios Digitales de la UE.